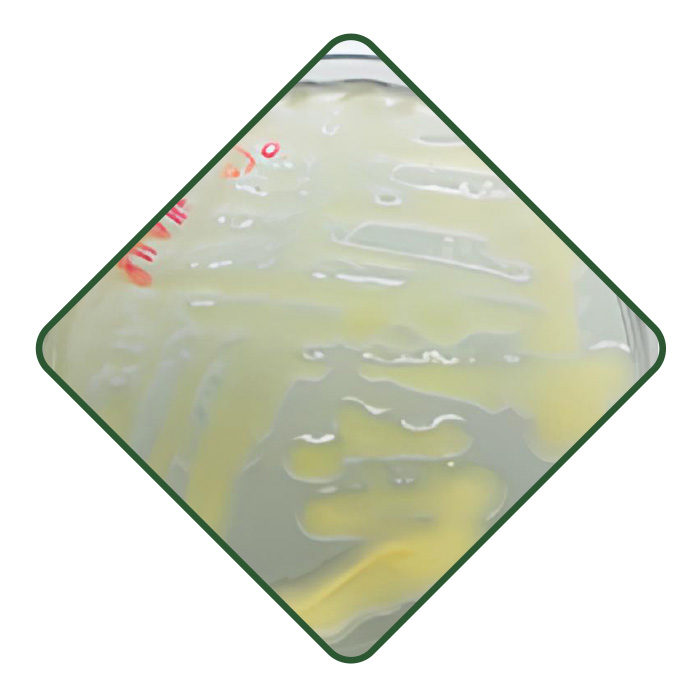

HYDRO-GREEN
HYDRO-GREEN
Rhizobium alamii PFC6 (A) Biostimulant microbien des plantes
BÉNÉFICES AGRONOMIQUES :

Hyper-productrice d’exopolysaccharides (EPS) = gel hydro rétenteur naturel
* Piège jusqu’à 300X sa masse en eau
* Augmentation du contact sol-racine
* Réduction du stress hydrique
* Optimisation de la rétention de l’eau sur les racines

Rétention des éléments nutritifs du sol

Production de phytohormones (IAA)
* Bénéfique pour la croissance et l’architecture racinaire des plantes


BÉNÉFICES AGRONOMIQUES :

Hyper-productrice d’exopolysaccharides (EPS) = gel hydro rétenteur naturel
* Piège jusqu’à 300X sa masse en eau
* Augmentation du contact sol-racine
* Réduction du stress hydrique
* Optimisation de la rétention de l’eau sur les racines

Rétention des éléments nutritifs du sol

Production de phytohormones (IAA)
* Bénéfique pour la croissance et l’architecture racinaire des plantes